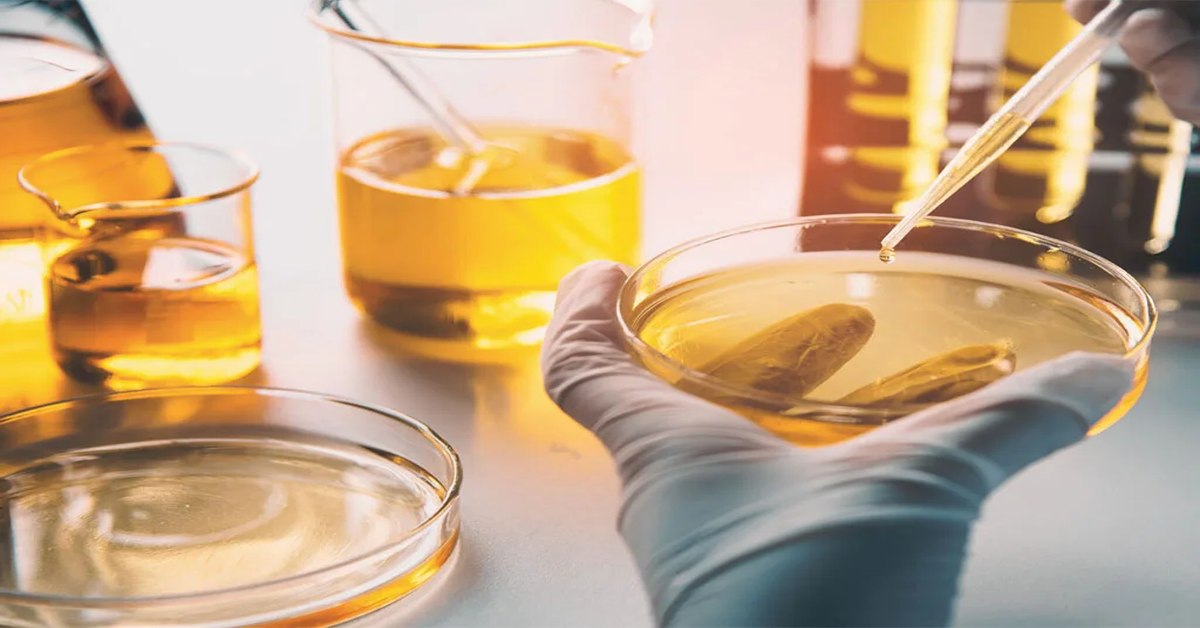
کیفیت-روغن-صنعتی

مقدمه
در صنایع مختلف، روغن صنعتی نقش حیاتی در روانکاری، کاهش اصطکاک و محافظت از تجهیزات دارد. کیفیت پایین روغن میتواند باعث افزایش سایش قطعات، کاهش راندمان و توقف ناگهانی خط تولید شود. به همین دلیل، بررسی کیفیت روغن صنعتی یکی از اقدامات کلیدی در نگهداری پیشگیرانه محسوب میشود.
این بررسی شامل ارزیابی شاخصهای فیزیکی، شیمیایی و ظاهری روغن و همچنین انجام آنالیزهای آزمایشگاهی است. با پایش منظم و دقیق روغن، میتوان عمر تجهیزات را افزایش داد، هزینههای تعمیرات را کاهش داد و عملکرد سیستمهای صنعتی را بهینه نگه داشت.
بررسی کیفیت روغن صنعتی چیست و چرا اهمیت دارد؟
روغن صنعتی یکی از مهمترین عوامل در عملکرد پایدار تجهیزات مکانیکی محسوب میشود و نقش آن تنها به روانکاری محدود نیست. این نوع روغن وظیفه کاهش اصطکاک، انتقال حرارت، جلوگیری از خوردگی و محافظت از قطعات داخلی دستگاهها را بر عهده دارد. با گذشت زمان و در اثر شرایط کاری، ویژگیهای شیمیایی و فیزیکی روغن تغییر میکند و همین موضوع میتواند عملکرد کل سیستم را تحت تأثیر قرار دهد.
فرآیند بررسی کیفیت روغن صنعتی به مجموعه اقداماتی گفته میشود که با هدف ارزیابی سلامت روغن و میزان کارایی آن انجام میگیرد. این بررسی میتواند شامل مشاهده ظاهری، اندازهگیری شاخصهای فنی یا انجام آزمایشهای تخصصی باشد. بسیاری از خرابیهای ناگهانی ماشینآلات در صنایع مختلف، نتیجه استفاده طولانیمدت از روغنی است که کیفیت اولیه خود را از دست داده اما هنوز تعویض نشده است.
وقتی روغن دچار اکسیداسیون، آلودگی یا کاهش ویسکوزیته میشود، لایه محافظ میان قطعات از بین میرود و تماس فلز با فلز افزایش پیدا میکند. این مسئله باعث افزایش دما، مصرف انرژی بیشتر و در نهایت استهلاک شدید تجهیزات خواهد شد. بنابراین پایش منظم وضعیت روغن نهتنها یک اقدام نگهداری ساده نیست، بلکه بخشی از استراتژی نگهداری پیشگیرانه در صنایع مدرن به شمار میآید.
اهمیت این موضوع زمانی بیشتر مشخص میشود که بدانیم هزینه توقف خط تولید یا تعمیر یک دستگاه صنعتی معمولاً چندین برابر هزینه پایش و آنالیز روغن است. به همین دلیل، سازمانهای صنعتی پیشرفته برنامه مشخصی برای کنترل وضعیت روغن دارند تا از بروز خرابیهای پرهزینه جلوگیری کنند.
کیفیت روغن صنعتی چه تأثیری بر عمر تجهیزات دارد؟
کیفیت روغن مستقیماً با طول عمر تجهیزات صنعتی ارتباط دارد. زمانی که روغن در شرایط استاندارد قرار داشته باشد، یک لایه محافظ پایدار میان سطوح فلزی ایجاد میکند و مانع تماس مستقیم قطعات میشود. این لایه باعث کاهش اصطکاک و جلوگیری از ساییدگی زودرس قطعات حساس مانند یاتاقانها، چرخدندهها و پمپها میشود.
در مقابل، روغنی که خواص خود را از دست داده باشد دیگر قادر به ایجاد این لایه محافظ نیست. افزایش ذرات سایشی، ورود گردوغبار یا آب و همچنین تخریب افزودنیهای شیمیایی باعث میشود عملکرد روانکاری به شدت کاهش پیدا کند. در چنین شرایطی دمای کاری دستگاه بالا میرود و فشار بیشتری به اجزای مکانیکی وارد میشود.
در فرآیند بررسی کیفیت روغن صنعتی مشخص میشود که آیا روغن هنوز قابلیت محافظت از قطعات را دارد یا خیر. نتایج این بررسی به تیم نگهداری کمک میکند قبل از ایجاد آسیب جدی، اقدام اصلاحی انجام دهند. بسیاری از کارخانهها با اجرای برنامه پایش روغن توانستهاند عمر مفید تجهیزات خود را تا چندین سال افزایش دهند.
نکته مهم این است که کیفیت مناسب روغن فقط باعث کاهش خرابی نمیشود، بلکه بازده انرژی را نیز افزایش میدهد. اصطکاک کمتر به معنای مصرف برق پایینتر و عملکرد نرمتر ماشینآلات است. بنابراین کنترل وضعیت روغن در واقع سرمایهگذاری مستقیم روی دوام تجهیزات و کاهش هزینههای عملیاتی محسوب میشود.
هزینههای ناشی از استفاده از روغن بیکیفیت
استفاده از روغن نامناسب یا روغنی که کیفیت خود را از دست داده، یکی از دلایل اصلی افزایش هزینههای پنهان در صنایع است. بسیاری از مدیران تنها به هزینه خرید روغن توجه میکنند، در حالی که هزینه واقعی زمانی ایجاد میشود که عملکرد دستگاهها کاهش پیدا کند یا خرابیهای زنجیرهای رخ دهد.
روغن بیکیفیت باعث افزایش اصطکاک داخلی میشود و همین موضوع مصرف انرژی را بالا میبرد. دستگاه برای انجام همان مقدار کار، انرژی بیشتری مصرف میکند و این مسئله در مقیاس صنعتی هزینه قابل توجهی ایجاد میکند. علاوه بر آن، افزایش دما موجب تخریب سریعتر قطعات و کاهش عمر مفید آنها میشود.
با انجام منظم بررسی کیفیت روغن صنعتی میتوان پیش از بروز این هزینهها وضعیت روغن را تشخیص داد. این اقدام کمک میکند زمان تعویض روغن دقیقتر تعیین شود و از تعویض زودهنگام یا دیرهنگام جلوگیری گردد. هر دو حالت میتوانند هزینهزا باشند؛ تعویض زودهنگام باعث هدررفت منابع و تعویض دیرهنگام منجر به آسیب تجهیزات میشود.
همچنین خرابی ناگهانی دستگاهها میتواند باعث توقف خط تولید شود؛ اتفاقی که معمولاً بیشترین ضرر مالی را به همراه دارد. بنابراین پایش کیفیت روغن در واقع ابزاری برای مدیریت هزینه و کاهش ریسک عملیاتی در محیطهای صنعتی است.

نقش پایش روغن در نگهداری پیشگیرانه (PM)
نگهداری پیشگیرانه یا PM روشی مدیریتی است که هدف آن جلوگیری از خرابی تجهیزات قبل از وقوع مشکل است. در این رویکرد، بهجای تعمیر پس از خرابی، وضعیت اجزای حیاتی دستگاه بهطور مداوم پایش میشود و روغن یکی از مهمترین شاخصهای ارزیابی سلامت ماشینآلات محسوب میشود.
روغن در حین کار دستگاه اطلاعات ارزشمندی از شرایط داخلی سیستم در خود نگه میدارد. وجود ذرات فلزی، تغییر ویسکوزیته یا افزایش میزان آلودگی میتواند نشانه آغاز یک مشکل مکانیکی باشد. به همین دلیل متخصصان تعمیرات از آنالیز روغن بهعنوان یک ابزار تشخیصی استفاده میکنند.
در فرآیند بررسی کیفیت روغن صنعتی دادههایی به دست میآید که امکان پیشبینی خرابیها را فراهم میکند. برای مثال افزایش ذرات فلزی خاص میتواند نشاندهنده سایش یک قطعه مشخص باشد. این اطلاعات کمک میکند تعمیرات قبل از آسیب جدی انجام شود.
اجرای پایش روغن در برنامه PM باعث کاهش توقفهای اضطراری، افزایش قابلیت اطمینان تجهیزات و برنامهریزی دقیقتر تعمیرات میشود. در واقع روغن مانند یک حسگر داخلی عمل میکند که وضعیت سلامت دستگاه را بدون نیاز به باز کردن آن نشان میدهد.
چه زمانی باید بررسی کیفیت روغن صنعتی انجام شود؟
یکی از سوالات رایج در محیطهای صنعتی این است که چه زمانی باید وضعیت روغن بررسی شود. برخلاف تصور عمومی، تعویض یا کنترل روغن نباید فقط بر اساس زمان ثابت انجام شود، زیرا شرایط کاری تجهیزات، دما، میزان بار و محیط عملیاتی تأثیر مستقیمی بر عمر روغن دارند.
زمان مناسب برای بررسی کیفیت روغن صنعتی معمولاً بر اساس ترکیبی از ساعت کارکرد دستگاه، شرایط محیطی و توصیه سازنده تعیین میشود. در تجهیزاتی که تحت بار سنگین فعالیت میکنند یا در محیطهای آلوده قرار دارند، روغن سریعتر دچار تخریب میشود و نیاز به پایش مکرر دارد.
یکی از بهترین روشها، ایجاد برنامه زمانبندی پایش روغن است. در این برنامه نمونهگیری در بازههای مشخص انجام میشود تا روند تغییرات روغن بررسی گردد. این کار کمک میکند الگوی فرسایش روغن در هر دستگاه شناخته شود و تصمیمگیریها دقیقتر انجام گیرد.
همچنین شرایط غیرعادی مانند افزایش دمای دستگاه، صدای غیرمعمول یا کاهش راندمان میتواند نشانه نیاز فوری به بررسی روغن باشد. در چنین مواقعی نباید منتظر زمانبندی دورهای ماند، زیرا ممکن است مشکل در حال گسترش باشد.
در صنایع پیشرفته، زمان بررسی روغن بهصورت دادهمحور تعیین میشود؛ یعنی نتایج آنالیز قبلی مشخص میکند که فاصله بررسی بعدی چه مقدار باشد. این روش باعث کاهش هزینههای نگهداری و افزایش اطمینان عملیاتی میشود.
بررسی دورهای روغن صنعتی در کارخانهها
بررسی دورهای روغن یکی از پایههای اصلی مدیریت نگهداری تجهیزات در کارخانهها است. در این روش، روغن در بازههای زمانی مشخص نمونهگیری و تحلیل میشود تا تغییرات آن بهصورت روندی بررسی گردد. این کار امکان تشخیص مشکلات پنهان را قبل از تبدیل شدن به خرابی جدی فراهم میکند.
در فرآیند بررسی کیفیت روغن صنعتی بهصورت دورهای، پارامترهایی مانند ویسکوزیته، میزان آلودگی و وضعیت افزودنیها کنترل میشوند. مقایسه نتایج هر دوره با نتایج قبلی نشان میدهد روغن با چه سرعتی در حال تخریب است و آیا شرایط کاری دستگاه طبیعی است یا خیر.
کارخانههایی که برنامه پایش منظم دارند معمولاً با خرابیهای ناگهانی کمتری مواجه میشوند. دلیل آن این است که تغییرات کوچک پیش از تبدیل شدن به مشکل بزرگ شناسایی میشوند. علاوه بر این، دادههای ثبتشده در طول زمان به مهندسان کمک میکند الگوی عملکرد تجهیزات را بهتر درک کنند.
اجرای بررسی دورهای همچنین باعث بهینهسازی مصرف روغن میشود، زیرا تعویض روغن دقیقاً زمانی انجام میشود که واقعاً لازم است، نه صرفاً بر اساس حدس یا تجربه شخصی.
علائم هشداردهنده نیاز به تست روغن
گاهی تجهیزات صنعتی پیش از بروز خرابی، نشانههایی از کاهش کیفیت روغن را نشان میدهند. شناخت این علائم میتواند از آسیبهای جدی جلوگیری کند. افزایش دمای کاری یکی از مهمترین نشانهها است، زیرا کاهش خاصیت روانکاری باعث افزایش اصطکاک میشود.
صدای غیرعادی، لرزش بیش از حد یا کاهش راندمان دستگاه نیز میتواند نشاندهنده افت کیفیت روغن باشد. تغییر رنگ شدید، بوی سوختگی یا کف کردن روغن از دیگر علائم رایج هستند که نباید نادیده گرفته شوند. در چنین شرایطی انجام فوری بررسی کیفیت روغن صنعتی ضروری است تا مشخص شود مشکل ناشی از آلودگی، اکسیداسیون یا تخریب افزودنیها است.
تأخیر در بررسی ممکن است باعث آسیب دائمی به قطعات شود. اپراتورها و تکنسینهای نگهداری باید آموزش ببینند تا این نشانهها را تشخیص دهند. واکنش سریع به علائم هشداردهنده معمولاً هزینه بسیار کمتری نسبت به تعمیرات اساسی خواهد داشت.

بررسی روغن قبل از تعویض یا خرید مجدد
یکی از اشتباهات رایج در بسیاری از صنایع، تعویض روغن بدون ارزیابی وضعیت واقعی آن است. گاهی روغن هنوز قابلیت استفاده دارد و تعویض زودهنگام تنها باعث افزایش هزینهها میشود. از طرف دیگر، استفاده بیش از حد از روغن فرسوده میتواند خسارت جدی ایجاد کند.
انجام بررسی کیفیت روغن صنعتی قبل از تصمیمگیری برای تعویض، کمک میکند وضعیت واقعی روغن مشخص شود. اگر شاخصهای عملکردی هنوز در محدوده استاندارد باشند، میتوان با اطمینان از ادامه استفاده از روغن بهره برد.
همچنین هنگام خرید مجدد روغن، بررسی نمونه روغن جدید اهمیت دارد تا از اصالت و کیفیت آن اطمینان حاصل شود. این کار بهویژه در بازارهایی که احتمال وجود محصولات تقلبی وجود دارد بسیار حیاتی است. این رویکرد باعث میشود تصمیمات نگهداری بر اساس داده و تحلیل انجام شود، نه صرفاً بر اساس زمانبندی ثابت یا تجربه فردی.
مهمترین شاخصها در بررسی کیفیت روغن صنعتی
برای ارزیابی سلامت روغن، تنها مشاهده ظاهری کافی نیست و باید مجموعهای از شاخصهای فنی مورد بررسی قرار گیرد. هر روغن صنعتی دارای ویژگیهایی است که نشان میدهد آیا هنوز توانایی محافظت از تجهیزات را دارد یا خیر. شناخت این شاخصها به کارشناسان تعمیرات کمک میکند تصمیمات دقیقتری درباره ادامه استفاده یا تعویض روغن بگیرند.
در فرآیند بررسی کیفیت روغن صنعتی معمولاً چند پارامتر اصلی مورد توجه قرار میگیرد که مهمترین آنها ویسکوزیته، میزان آلودگی، عدد اسیدی و مقدار آب موجود در روغن است. تغییر هر یک از این عوامل میتواند نشاندهنده نوع خاصی از مشکل در سیستم باشد. برای مثال کاهش ویسکوزیته معمولاً به معنی تخریب ساختار روغن یا رقیق شدن آن است، در حالی که افزایش آن میتواند نشانه اکسیداسیون یا آلودگی باشد.
عدد اسیدی یا TAN یکی دیگر از شاخصهای مهم است که میزان تخریب شیمیایی روغن را نشان میدهد. افزایش این عدد معمولاً بیانگر اکسید شدن روغن و کاهش خاصیت محافظتی آن است. همچنین وجود آب در روغن یکی از خطرناکترین آلودگیها محسوب میشود، زیرا باعث کاهش روانکاری و ایجاد خوردگی در قطعات فلزی میشود.
بررسی همزمان این شاخصها تصویری دقیق از وضعیت عملکرد روغن ارائه میدهد. نکته مهم این است که هیچ شاخصی بهتنهایی معیار تصمیمگیری نیست و باید مجموعه دادهها در کنار هم تحلیل شوند. استفاده از این رویکرد تحلیلی باعث میشود نگهداری تجهیزات از حالت واکنشی خارج شده و به یک فرآیند پیشبینانه تبدیل شود.
ویسکوزیته (Viscosity)
ویسکوزیته مهمترین ویژگی فیزیکی روغن صنعتی است و میزان مقاومت آن در برابر جریان را نشان میدهد. این ویژگی تعیین میکند روغن تا چه اندازه میتواند یک لایه محافظ پایدار بین قطعات متحرک ایجاد کند. اگر ویسکوزیته کمتر از حد استاندارد باشد، فیلم روغن نازک شده و تماس فلز با فلز افزایش مییابد.
در فرآیند بررسی کیفیت روغن صنعتی اندازهگیری ویسکوزیته اولین مرحله ارزیابی محسوب میشود. تغییر این شاخص معمولاً نشاندهنده مشکلاتی مانند آلودگی سوخت، تخریب حرارتی یا ترکیب شدن با روغن دیگر است. افزایش بیش از حد ویسکوزیته نیز میتواند باعث افزایش مصرف انرژی و کاهش راندمان سیستم شود.
ویسکوزیته تحت تأثیر دما قرار دارد، بنابراین اندازهگیری آن باید در شرایط استاندارد انجام شود. در بسیاری از صنایع، مقایسه ویسکوزیته فعلی با مقدار اولیه ثبتشده هنگام استفاده از روغن جدید، معیار اصلی تشخیص سلامت روغن است.
کنترل منظم این شاخص کمک میکند عملکرد روانکاری در سطح مطلوب باقی بماند و از سایش زودرس قطعات جلوگیری شود. به همین دلیل بسیاری از برنامههای پایش وضعیت تجهیزات، ویسکوزیته را بهعنوان شاخص کلیدی سلامت روغن در نظر میگیرند.
میزان آلودگی و ذرات معلق
آلودگی یکی از اصلیترین عوامل کاهش عمر روغن و تجهیزات صنعتی است. ذرات گردوغبار، برادههای فلزی و آلودگیهای محیطی میتوانند وارد سیستم شوند و عملکرد روانکاری را مختل کنند. این ذرات مانند سمباده عمل کرده و باعث سایش تدریجی قطعات میشوند.
در طی بررسی کیفیت روغن صنعتی میزان ذرات معلق با استفاده از روشهای مختلفی مانند فیلترگذاری یا آنالیز ذرات اندازهگیری میشود. افزایش ناگهانی ذرات فلزی معمولاً نشانه آغاز فرسایش در یکی از اجزای داخلی دستگاه است و میتواند هشدار اولیه خرابی باشد.
منابع آلودگی ممکن است شامل نفوذ هوا، خرابی فیلترها، نشتی آببندها یا شرایط محیطی نامناسب باشند. شناسایی منشأ آلودگی اهمیت زیادی دارد، زیرا تنها تعویض روغن بدون رفع علت اصلی مشکل، راهحل دائمی نخواهد بود.
کنترل سطح آلودگی باعث افزایش عمر روغن، کاهش اصطکاک و جلوگیری از خرابیهای ناگهانی میشود. به همین دلیل سیستمهای فیلتراسیون مناسب و نمونهگیری صحیح نقش مهمی در حفظ کیفیت روغن ایفا میکنند.

عدد اسیدی (TAN) و اکسیداسیون
عدد اسیدی یا Total Acid Number یکی از شاخصهای شیمیایی مهم برای ارزیابی وضعیت روغن است. این عدد میزان ترکیبات اسیدی ایجادشده در اثر اکسیداسیون روغن را نشان میدهد. با گذشت زمان و قرار گرفتن روغن در معرض حرارت و اکسیژن، ساختار مولکولی آن تخریب میشود.
در فرآیند بررسی کیفیت روغن صنعتی افزایش عدد اسیدی معمولاً نشانه پایان عمر مفید روغن است. ترکیبات اسیدی میتوانند باعث خوردگی قطعات فلزی و تشکیل لجن در سیستم شوند. این رسوبات مسیرهای عبور روغن را مسدود کرده و عملکرد سیستم را مختل میکنند.
اکسیداسیون معمولاً در دماهای بالا سریعتر رخ میدهد، به همین دلیل تجهیزات با بار حرارتی زیاد نیاز به پایش دقیقتری دارند. اندازهگیری دورهای TAN کمک میکند زمان تعویض روغن پیش از ایجاد آسیب مشخص شود. کنترل این شاخص نهتنها از خوردگی جلوگیری میکند، بلکه باعث حفظ پایداری شیمیایی روغن و عملکرد بهینه سیستم نیز میشود.
میزان آب موجود در روغن
وجود آب در روغن صنعتی یکی از خطرناکترین انواع آلودگی محسوب میشود. حتی مقدار کم آب میتواند خاصیت روانکاری را کاهش داده و باعث زنگزدگی قطعات شود. آب ممکن است از طریق رطوبت محیط، نشتی سیستم خنککننده یا میعان وارد روغن شود.
در زمان بررسی کیفیت روغن صنعتی اندازهگیری میزان آب اهمیت زیادی دارد، زیرا بسیاری از آسیبها در مراحل اولیه قابل مشاهده نیستند. آب باعث تشکیل امولسیون شده و ظاهر روغن را شیریرنگ میکند، اما در برخی موارد حضور آن تنها از طریق آزمایش قابل تشخیص است.
افزایش رطوبت همچنین سرعت اکسیداسیون روغن را بالا میبرد و موجب کاهش عمر افزودنیهای محافظ میشود. این موضوع میتواند عملکرد کل سیستم روانکاری را مختل کند. استفاده از سیستمهای آبگیر، کنترل دمای مخازن و نگهداری صحیح روغن از مهمترین راهکارهای جلوگیری از ورود آب به سیستم هستند. پایش منظم این شاخص نقش مهمی در افزایش دوام تجهیزات دارد.
بررسی کیفیت روغن صنعتی از روی رنگ و ظاهر روغن
مشاهده ظاهری روغن یکی از سریعترین و در دسترسترین روشها برای ارزیابی اولیه وضعیت آن است. هرچند این روش جایگزین آزمایشهای تخصصی نیست، اما میتواند نشانههای مهمی از تغییرات شیمیایی یا آلودگی روغن ارائه دهد. اپراتورها معمولاً اولین افرادی هستند که با مشاهده تغییرات ظاهری میتوانند وجود مشکل را تشخیص دهند.
در فرآیند بررسی کیفیت روغن صنعتی توجه به رنگ، شفافیت، بو و میزان کف اهمیت زیادی دارد. روغن سالم معمولاً شفاف و یکنواخت است، در حالی که تیرگی شدید یا کدر شدن میتواند نشانه اکسیداسیون یا ورود آلودگی باشد. با این حال، باید توجه داشت که تغییر رنگ همیشه به معنای خرابی کامل روغن نیست و نیاز به بررسی بیشتر دارد.
وجود حباب یا کف روی سطح روغن میتواند نشاندهنده ورود هوا یا تخریب افزودنیهای ضدکف باشد. همچنین بوی سوختگی اغلب به دلیل قرار گرفتن روغن در دمای بیش از حد مجاز ایجاد میشود. این نشانهها معمولاً هشدار اولیه مشکلاتی هستند که در صورت بیتوجهی میتوانند به خرابی جدی تجهیزات منجر شوند.
بررسی ظاهری بهعنوان یک ابزار پایش روزانه بسیار ارزشمند است، زیرا بدون تجهیزات پیچیده میتوان تغییرات غیرعادی را شناسایی کرد. ترکیب این روش با آنالیزهای دورهای بهترین نتیجه را در مدیریت سلامت روغن و تجهیزات فراهم میکند.
تغییر رنگ روغن چه معنایی دارد؟
تغییر رنگ یکی از اولین نشانههایی است که هنگام بررسی روغن جلب توجه میکند. روغن تازه معمولاً رنگ روشن و شفاف دارد، اما با گذشت زمان و قرار گرفتن در شرایط کاری، ممکن است تیرهتر شود. این تغییر میتواند ناشی از اکسیداسیون، افزایش دما یا تجمع ذرات معلق باشد.
در روند بررسی کیفیت روغن صنعتی باید توجه داشت که تیرگی همیشه به معنای غیرقابل استفاده بودن روغن نیست. برخی افزودنیها در حین عملکرد طبیعی تغییر رنگ ایجاد میکنند. بنابراین رنگ تنها یک شاخص اولیه است و باید همراه با سایر آزمایشها ارزیابی شود.
اگر روغن به رنگ سیاه غلیظ یا بسیار کدر تبدیل شود، احتمال وجود رسوبات یا تخریب شدید شیمیایی بالا است. در چنین شرایطی بررسی دقیقتر ضروری خواهد بود. ثبت تغییرات رنگ در طول زمان میتواند اطلاعات ارزشمندی درباره شرایط عملکرد دستگاه ارائه دهد و به تشخیص زودهنگام مشکلات کمک کند.

کف کردن روغن نشانه چیست؟
ایجاد کف در روغن صنعتی معمولاً نشانه ورود هوا یا کاهش عملکرد افزودنیهای ضدکف است. کف باعث میشود جریان روغن ناپایدار شود و توانایی انتقال حرارت و روانکاری کاهش پیدا کند. این موضوع میتواند به افزایش دمای سیستم و آسیب قطعات منجر شود.
در هنگام بررسی کیفیت روغن صنعتی مشاهده کف پایدار روی سطح روغن باید جدی گرفته شود. دلایل ایجاد کف میتواند شامل سطح پایین روغن، نشتی در مسیر مکش پمپ یا آلودگی شیمیایی باشد. حبابهای هوا همچنین باعث کاهش استحکام فیلم روغن میشوند و فشار بیشتری به قطعات وارد میکنند.
در سیستمهای هیدرولیک، وجود کف حتی میتواند باعث عملکرد ناپایدار تجهیزات شود. بررسی منبع ورود هوا و اطمینان از سلامت فیلترها و اتصالات، اولین اقدام برای رفع این مشکل است.
بوی غیرعادی روغن صنعتی
بوی روغن اطلاعات مهمی درباره وضعیت شیمیایی آن ارائه میدهد. روغن سالم معمولاً بوی ملایمی دارد، اما بوی سوختگی یا بوی تند میتواند نشانه تخریب حرارتی باشد. این حالت زمانی رخ میدهد که روغن در معرض دمای بیش از حد یا اصطکاک بالا قرار گرفته باشد.
در فرآیند بررسی کیفیت روغن صنعتی توجه به بو میتواند به تشخیص سریع مشکلات کمک کند. بوی سوختگی اغلب همراه با کاهش ویسکوزیته و تشکیل رسوبات است که نشاندهنده کاهش شدید کارایی روغن است.
در برخی موارد، بوی غیرعادی میتواند ناشی از آلودگی خارجی یا ترکیب شدن روغن با مواد دیگر باشد. تشخیص زودهنگام این تغییرات از بروز آسیبهای جدی جلوگیری میکند. بنابراین بررسی حسی روغن، در کنار آزمایشهای فنی، یک روش ساده اما مؤثر برای پایش روزانه وضعیت روغن محسوب میشود.
تشخیص کیفیت روغن صنعتی با بررسی ویسکوزیته
ویسکوزیته یکی از مهمترین ویژگیهای فیزیکی روغن صنعتی است که نقش تعیینکنندهای در عملکرد صحیح سیستمهای مکانیکی دارد. این شاخص نشان میدهد روغن تا چه اندازه در برابر جریان مقاومت میکند و آیا قادر است لایه محافظ مناسبی میان قطعات متحرک ایجاد کند یا خیر. اگر ویسکوزیته خارج از محدوده استاندارد قرار گیرد، عملکرد روانکاری بهشدت کاهش پیدا میکند و احتمال سایش قطعات افزایش مییابد.
در فرآیند بررسی کیفیت روغن صنعتی، کنترل ویسکوزیته معمولاً اولین و اساسیترین مرحله محسوب میشود. کاهش ویسکوزیته میتواند ناشی از رقیق شدن روغن، ورود سوخت یا تخریب ساختار مولکولی آن در اثر حرارت بالا باشد. در مقابل، افزایش بیش از حد ویسکوزیته اغلب به دلیل اکسیداسیون، آلودگی یا تشکیل رسوبات رخ میدهد. هر دو حالت میتوانند باعث کاهش راندمان دستگاه و افزایش مصرف انرژی شوند.
یکی از نکات مهم در ارزیابی ویسکوزیته، توجه به دمای اندازهگیری است. روغنها در دماهای مختلف رفتار متفاوتی دارند و به همین دلیل اندازهگیری باید در شرایط استاندارد انجام شود تا نتایج قابل مقایسه باشند. بسیاری از واحدهای صنعتی مقدار ویسکوزیته روغن نو را بهعنوان مرجع ثبت میکنند و تغییرات بعدی را نسبت به همان مقدار میسنجند.
کنترل منظم این شاخص کمک میکند زمان مناسب تعویض روغن مشخص شود و از خرابیهای ناشی از روانکاری نامناسب جلوگیری گردد. در واقع، پایش ویسکوزیته نهتنها وضعیت روغن را نشان میدهد، بلکه اطلاعاتی درباره شرایط کاری تجهیزات نیز ارائه میدهد و میتواند نشانهای از وجود مشکل در سیستم باشد.
بررسی کیفیت روغن صنعتی با تست آلودگی و ذرات فلزی
آلودگی یکی از مهمترین عوامل کاهش عملکرد روغن و افزایش استهلاک تجهیزات صنعتی است. ورود ذرات خارجی به روغن میتواند باعث ایجاد سایش تدریجی در قطعات شود و در صورت ادامه این روند، خرابیهای جدی و پرهزینهای ایجاد کند. به همین دلیل کنترل میزان آلودگی بخش مهمی از برنامه نگهداری تجهیزات محسوب میشود.
در فرآیند بررسی کیفیت روغن صنعتی، تحلیل ذرات معلق و فلزی اطلاعات ارزشمندی درباره وضعیت داخلی دستگاه ارائه میدهد. وجود ذرات فلزی معمولاً نشانه سایش قطعاتی مانند چرخدندهها، یاتاقانها یا شفتها است. نوع فلز شناساییشده حتی میتواند مشخص کند کدام بخش دستگاه در حال فرسایش است. این ویژگی باعث شده آنالیز ذرات به یکی از ابزارهای مهم پایش وضعیت تبدیل شود.
آلودگی ممکن است از منابع مختلفی وارد روغن شود؛ از جمله نفوذ گردوغبار محیط، خرابی فیلترها، ورود رطوبت یا باقیماندن ذرات حاصل از فرآیند تولید. اگر این آلودگیها بهموقع شناسایی نشوند، مانند مواد ساینده عمل کرده و سطح قطعات را تخریب میکنند. نتیجه این فرایند افزایش اصطکاک، تولید حرارت بیشتر و کاهش عمر مفید تجهیزات خواهد بود.
استفاده از سیستمهای فیلتراسیون مناسب، نمونهگیری صحیح و بررسی دورهای روغن میتواند میزان آلودگی را در سطح قابلقبول نگه دارد. تحلیل روند تغییرات آلودگی نیز به کارشناسان کمک میکند مشکلات احتمالی را پیش از وقوع خرابی تشخیص دهند. به همین دلیل تست ذرات فلزی نهتنها وضعیت روغن، بلکه سلامت کلی ماشینآلات را نیز مشخص میکند.
روشهای آزمایشگاهی برای بررسی کیفیت روغن صنعتی
در بسیاری از موارد، ارزیابی ظاهری یا بررسیهای ساده نمیتواند تصویر دقیقی از وضعیت واقعی روغن ارائه دهد. به همین دلیل آزمایشهای آزمایشگاهی بهعنوان دقیقترین روش تشخیص سلامت روغن در صنایع پیشرفته شناخته میشوند. این آزمایشها امکان تحلیل ویژگیهای فیزیکی و شیمیایی روغن را فراهم میکنند و اطلاعاتی ارائه میدهند که با روشهای معمول قابل مشاهده نیست.
در فرآیند بررسی کیفیت روغن صنعتی، آزمایشگاهها با استفاده از تجهیزات تخصصی پارامترهایی مانند میزان اکسیداسیون، عدد اسیدی، مقدار آب، سطح آلودگی و عناصر فلزی را اندازهگیری میکنند. هر یک از این دادهها میتواند نشاندهنده نوع خاصی از مشکل در سیستم باشد. برای مثال افزایش عناصر فلزی خاص ممکن است نشاندهنده سایش یک قطعه مشخص در دستگاه باشد.
یکی از مزیتهای مهم آزمایشهای آزمایشگاهی، امکان تحلیل روند تغییرات روغن در طول زمان است. با مقایسه نتایج چند نمونه متوالی میتوان سرعت تخریب روغن را تعیین کرد و زمان مناسب تعویض آن را پیشبینی نمود. این رویکرد باعث میشود نگهداری تجهیزات از حالت حدسی خارج شده و بر پایه دادههای واقعی انجام شود.
نمونهگیری صحیح نقش بسیار مهمی در دقت نتایج دارد. اگر نمونه از محل یا زمان نامناسب گرفته شود، نتایج ممکن است گمراهکننده باشند. به همین دلیل معمولاً دستورالعمل مشخصی برای برداشت نمونه روغن در صنایع وجود دارد.
استفاده از آزمایشهای تخصصی نهتنها باعث افزایش عمر روغن میشود، بلکه به کاهش توقفهای ناگهانی و بهینهسازی هزینههای نگهداری نیز کمک میکند. به همین علت بسیاری از کارخانههای مدرن برنامه آنالیز دورهای روغن را بهعنوان بخشی از استراتژی نگهداری خود اجرا میکنند.
بررسی کیفیت روغن صنعتی با آنالیز روغن (Oil Analysis)
آنالیز روغن یکی از پیشرفتهترین روشهای پایش وضعیت تجهیزات صنعتی است که فراتر از یک آزمایش ساده عمل میکند. در این روش، روغن بهعنوان منبع اطلاعاتی در نظر گرفته میشود که وضعیت داخلی دستگاه را منعکس میکند. به بیان دیگر، روغن مانند یک گزارشگر دائمی از شرایط عملکرد ماشینآلات عمل میکند.
در فرآیند بررسی کیفیت روغن صنعتی با استفاده از آنالیز روغن، سه بخش اصلی مورد ارزیابی قرار میگیرد: سلامت خود روغن، میزان آلودگی موجود و وضعیت سایش قطعات. ترکیب این سه نوع داده امکان تشخیص زودهنگام مشکلات مکانیکی را فراهم میکند. برای مثال افزایش ذرات فلزی خاص میتواند نشان دهد که یک یاتاقان در مراحل اولیه خرابی قرار دارد.
یکی از مزایای مهم آنالیز روغن، قابلیت پیشبینی خرابی قبل از وقوع آن است. این ویژگی باعث میشود تعمیرات بهصورت برنامهریزیشده انجام شود و از توقف ناگهانی خطوط تولید جلوگیری گردد. همچنین نتایج آنالیز کمک میکند فاصله زمانی تعویض روغن بهینه شود و از تعویضهای غیرضروری جلوگیری شود.
گزارش آنالیز روغن معمولاً شامل نمودارها و شاخصهایی است که روند تغییرات را نشان میدهد. تفسیر صحیح این دادهها اهمیت زیادی دارد، زیرا تصمیمگیریهای نگهداری بر اساس همین اطلاعات انجام میشود. به همین دلیل در بسیاری از صنایع، کارشناسان آموزشدیده مسئول تحلیل نتایج هستند.
بهطور کلی، آنالیز روغن پلی میان نگهداری سنتی و نگهداری هوشمند محسوب میشود و به سازمانها کمک میکند از رویکرد واکنشی فاصله گرفته و به سمت مدیریت پیشبینانه تجهیزات حرکت کنند.

نشانههای خراب شدن روغن صنعتی که نباید نادیده بگیرید
روغن صنعتی پیش از آنکه کاملاً کارایی خود را از دست بدهد، معمولاً نشانههایی از کاهش کیفیت بروز میدهد. شناخت این علائم به اپراتورها و کارشناسان تعمیرات کمک میکند قبل از ایجاد آسیب جدی، اقدامات لازم را انجام دهند. بسیاری از خرابیهای پرهزینه تجهیزات زمانی رخ میدهد که این نشانههای اولیه نادیده گرفته شوند.
یکی از رایجترین علائم، افزایش غیرعادی دمای دستگاه است. زمانی که روغن خاصیت روانکاری خود را از دست میدهد، اصطکاک میان قطعات افزایش یافته و در نتیجه حرارت بیشتری تولید میشود. این افزایش دما نهتنها به قطعات آسیب میزند، بلکه سرعت تخریب روغن را نیز بیشتر میکند و یک چرخه مخرب ایجاد میشود.
تغییر رنگ شدید، کدر شدن یا ایجاد رسوبات نیز از نشانههای مهم هستند. روغنی که بیش از حد تیره شده یا ذرات قابل مشاهده در آن وجود دارد، احتمالاً دچار اکسیداسیون یا آلودگی شده است. همچنین بوی سوختگی میتواند نشاندهنده قرار گرفتن روغن در دمای فراتر از محدوده مجاز باشد.
در فرآیند بررسی کیفیت روغن صنعتی توجه به صدا و لرزش دستگاه نیز اهمیت دارد. افزایش صداهای غیرمعمول یا لرزش میتواند نشانه کاهش لایه محافظ روغن و شروع سایش قطعات باشد. این علائم معمولاً قبل از خرابی کامل ظاهر میشوند و فرصت مناسبی برای اقدام پیشگیرانه فراهم میکنند.
نکته مهم این است که هیچکدام از این نشانهها نباید بهتنهایی ملاک تصمیمگیری باشد. بهترین رویکرد ترکیب مشاهده عملیاتی با آزمایشهای فنی است تا وضعیت واقعی روغن و تجهیزات بهطور دقیق مشخص شود.
اشتباهات رایج هنگام بررسی کیفیت روغن صنعتی
با وجود اهمیت بالای پایش روغن، بسیاری از صنایع هنگام ارزیابی وضعیت روغن دچار اشتباهاتی میشوند که میتواند منجر به تصمیمگیری نادرست و افزایش هزینههای نگهداری شود. این خطاها معمولاً ناشی از تکیه بر تجربه شخصی بهجای دادههای فنی و روشهای استاندارد است.
یکی از رایجترین اشتباهات، قضاوت درباره سلامت روغن تنها بر اساس رنگ آن است. در حالی که تغییر رنگ همیشه نشانه خرابی نیست و برخی افزودنیها بهطور طبیعی باعث تیره شدن روغن میشوند. تصمیمگیری صرفاً بر اساس ظاهر ممکن است باعث تعویض زودهنگام یا ادامه استفاده از روغن نامناسب شود.
اشتباه دیگر، نمونهگیری نادرست است. اگر نمونه روغن از محل نامناسب یا در زمان اشتباه گرفته شود، نتایج آزمایش نمیتواند وضعیت واقعی سیستم را نشان دهد. نمونهگیری باید در شرایط کاری پایدار و طبق دستورالعمل مشخص انجام شود تا دادهها قابل اعتماد باشند.
در بسیاری از موارد نیز فاصله زمانی بررسیها بیش از حد طولانی در نظر گرفته میشود. این موضوع باعث میشود تغییرات تدریجی روغن شناسایی نشود و مشکل زمانی آشکار شود که آسیب جدی رخ داده است. انجام منظم بررسی کیفیت روغن صنعتی کمک میکند روند تغییرات بهصورت پیوسته پایش شود و تصمیمات دقیقتری اتخاذ گردد.
از دیگر خطاهای رایج میتوان به استفاده از روغن نامتناسب با شرایط کاری، ترکیب برندهای مختلف روغن و بیتوجهی به نتایج آنالیز اشاره کرد. اصلاح این اشتباهات ساده میتواند تأثیر چشمگیری در افزایش عمر تجهیزات و کاهش هزینههای عملیاتی داشته باشد.
هر چند وقت یکبار باید کیفیت روغن صنعتی بررسی شود؟
تعیین زمان مناسب برای کنترل وضعیت روغن یکی از مهمترین بخشهای نگهداری تجهیزات صنعتی است. برخلاف تصور رایج، بررسی روغن نباید صرفاً بر اساس یک بازه زمانی ثابت انجام شود، زیرا شرایط کاری دستگاهها با یکدیگر تفاوت دارد و عوامل متعددی بر عمر روغن تأثیر میگذارند. میزان بار کاری، دمای محیط، نوع تجهیزات و میزان آلودگی محیطی همگی در سرعت تخریب روغن نقش دارند.
در برنامههای حرفهای نگهداری، بررسی کیفیت روغن صنعتی معمولاً بر اساس ساعت کارکرد دستگاه انجام میشود نه صرفاً گذشت زمان تقویمی. برای مثال تجهیزات سنگین یا دستگاههایی که بهصورت مداوم فعالیت میکنند، نیاز به پایش کوتاهمدتتری نسبت به ماشینآلات کمکار دارند. در بسیاری از صنایع، نمونهگیری ماهانه یا پس از تعداد مشخصی ساعت کارکرد، یک استاندارد رایج محسوب میشود.
همچنین شرایط غیرعادی مانند افزایش دما، کاهش راندمان، ایجاد صداهای غیرمعمول یا آلودگی محیطی بالا میتواند نیاز به بررسی فوری روغن را ایجاد کند. در چنین شرایطی نباید منتظر زمانبندی دورهای ماند، زیرا احتمال بروز آسیب در حال افزایش است.
بهترین رویکرد، استفاده از دادههای آنالیز قبلی برای تعیین فاصله بررسیهای بعدی است. این روش که مبتنی بر پایش وضعیت است، کمک میکند زمان تعویض روغن دقیقتر تعیین شود و از هزینههای اضافی جلوگیری گردد. در واقع هدف اصلی، بررسی روغن در زمانی است که هنوز فرصت پیشگیری وجود دارد، نه زمانی که خرابی رخ داده است.
جمعبندی
روغن صنعتی نقش حیاتی در عملکرد پایدار تجهیزات دارد و پایش مداوم آن میتواند از بسیاری از خرابیهای پرهزینه جلوگیری کند. همانطور که بررسی شد، ارزیابی وضعیت روغن تنها به مشاهده ظاهری محدود نمیشود و باید مجموعهای از شاخصهای فنی، آزمایشگاهی و عملیاتی در کنار هم بررسی شوند.
انجام منظم بررسی کیفیت روغن صنعتی باعث افزایش عمر تجهیزات، کاهش مصرف انرژی و جلوگیری از توقفهای ناگهانی خط تولید میشود. ترکیب روشهای ساده مانند بررسی ظاهری با آنالیزهای تخصصی، بهترین نتیجه را در مدیریت نگهداری فراهم میکند.
سازمانهایی که پایش روغن را بهعنوان بخشی از برنامه نگهداری پیشگیرانه اجرا میکنند، معمولاً هزینه تعمیرات کمتری داشته و قابلیت اطمینان تجهیزات در آنها بالاتر است. در نهایت، توجه به کیفیت روغن نه یک اقدام جانبی، بلکه یک سرمایهگذاری مستقیم برای افزایش بهرهوری و کاهش ریسک عملیاتی در محیطهای صنعتی محسوب میشود.

نظرتان را بگذارید
آدرس ایمیل شما منتشر نخواهد شد. فیلدهای الزامی علامت گذاری شده اند *